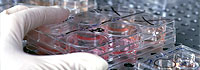

Reveladores y más que preocupantes datos de una encuesta nacional:
El 60% de los argentinos sienten
"cansancio, falta de energía y sueño"
Una encuesta realizada en todo el país reveló que el 60 por ciento de la población siente con frecuencia "cansancio, sueño o falta de energía" y cerca del 70 por ciento de ellos considera que esos síntomas podrían "debilitar sus defensas".
Pero a pesar de ello, según la misma encuesta, casi la mitad de los consultados "no hace nada por mantener las defensas en buenas condiciones".
El sondeo, que incluyó casi mil consultas, fue realizado por el Centro de Estudios de Opinión Pública (CEOP) y presentado por la Asociación Argentina de Alergia e Inmunología Clínica (AAAeIC), durante una conferencia de prensa en Buenos Aires.
En ese sentido, el presidente electo de la Asociación, Juan Carlos Ivancevich, señaló que "las personas tienen la percepción de que algo anda mal en su salud y de que podría cambiarse efectuando las acciones correctas, pero ni van al médico a consultar, ni adoptan los hábitos de vida que se supone son saludables".
La encuesta desarrollada por el CEOP fue llevada a cabo mediante 994 entrevistas telefónicas realizadas en Capital Federal, provincia de Buenos Aires, Córdoba, Santa Fe, Entre Ríos, Misiones, Corrientes, Chaco, Salta, Tucumán, Santiago del Estero, Jujuy, Catamarca, Mendoza, San Juan, Río Negro y Neuquén.
De acuerdo con los resultados del sondeo, la gente mencionó como principales pilares para conservar saludables las "defensas" del organismo, la práctica de actividad física (96 por ciento), el buen dormir (95 por ciento) y una alimentación equilibrada (el 94 por ciento de los consultados).
Pero, según el trabajo, cuando se consultó a los entrevistados acerca de sus propias conductas, se estableció que el 54 por ciento no tiene una alimentación equilibrada, el 36 por ciento no llega a dormir las horas que necesita, el 55 por ciento no puede tener un sueño profundo y 4 de cada 10 consultados ni siquiera hacía ejercicio físico.
"Es verdad que hay una brecha muy grande entre lo que la gente piensa que es bueno para su salud y lo que realmente hace. Hay un alto porcentaje de gente que sabe qué es bueno hacer, pero no lo hace. Y suponemos que no lo hace por falta de tiempo o porque no puede llevarlo a cabo", dijo a su vez Hugo Ghiani, secretario general de la AAAeIC.
El trabajo también determinó, respecto de las rinitis alérgicas -uno de los tipos de alergia más frecuentes- que si se consideran sus principales síntomas (estornudos, secreciones nasales y nariz tapada), casi el 15 por ciento de los entrevistados dijo haber tenido los tres durante el último año, y por más de dos semanas.
|
|